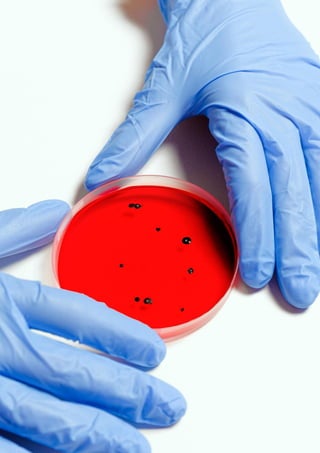
13

La rassegna di diritto alimentare e legislazione veterinaria n. 23 del 2020 fornisce un'informativa sulle normative recenti in materia di sicurezza alimentare e gestione veterinaria, con particolare attenzione agli aggiornamenti legislativi dell'Unione Europea e della Repubblica Italiana. Essa è disponibile gratuitamente e si propone come strumento di diffusione senza sostituire le fonti ufficiali. Inoltre, include informazioni sui consorzi di tutela e specifiche leggi relative a prodotti alimentari e giurisprudenza.